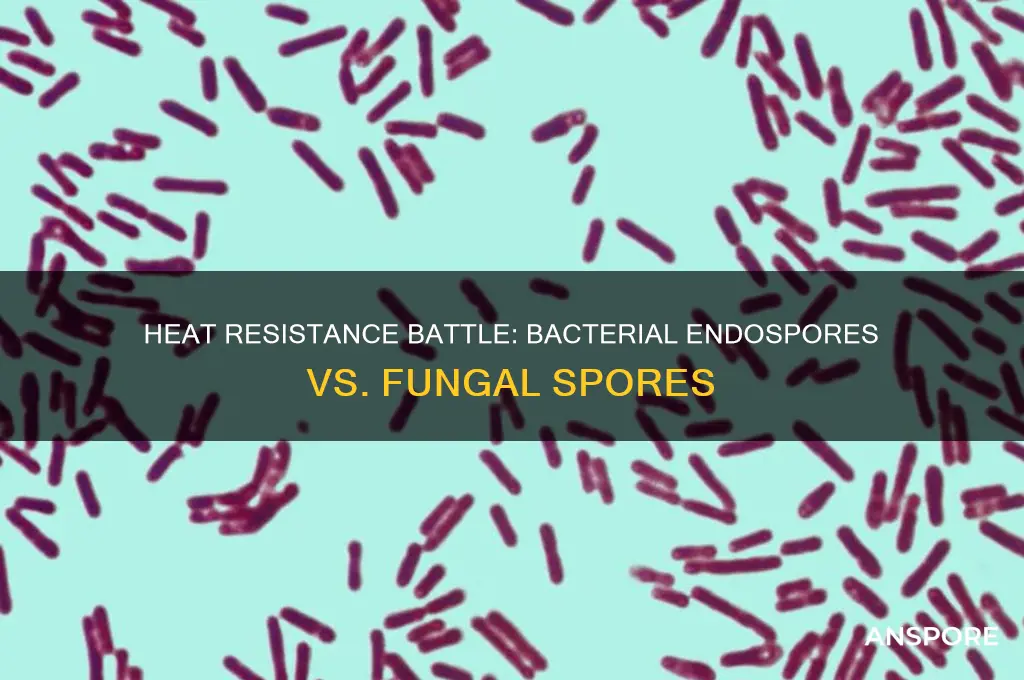
are bacterial endospores more heat resistant than fungal spores

Bacterial endospores and fungal spores are both highly resilient structures produced by microorganisms to survive harsh environmental conditions, but their heat resistance varies significantly. Bacterial endospores, formed by certain bacteria like *Clostridium* and *Bacillus*, are renowned for their extraordinary tolerance to extreme temperatures, often surviving autoclaving at 121°C for extended periods. In contrast, fungal spores, produced by organisms such as *Aspergillus* and *Neurospora*, exhibit lower heat resistance, typically inactivated at temperatures above 60-80°C. This disparity in heat tolerance is attributed to differences in spore structure, composition, and protective mechanisms, making bacterial endospores far more heat-resistant than their fungal counterparts. Understanding these differences is crucial for applications in food preservation, sterilization, and microbial control strategies.
| Characteristics | Values |
|---|---|
| Heat Resistance | Bacterial endospores are generally more heat-resistant than fungal spores. Bacterial endospores can survive temperatures up to 100°C for extended periods, while most fungal spores are less resistant, typically surviving at 60-80°C. |
| Survival Mechanisms | Bacterial endospores have a thick, multi-layered spore coat and low water content, enhancing heat resistance. Fungal spores rely on melanin and other pigments for protection but are less effective against high temperatures. |
| Dormancy Period | Bacterial endospores can remain dormant for years or even decades, surviving extreme conditions. Fungal spores also have long dormancy periods but are more susceptible to heat-induced damage. |
| Resistance to Sterilization | Bacterial endospores require autoclaving at 121°C for 15-30 minutes for effective sterilization. Fungal spores are generally eliminated at lower temperatures and shorter durations. |
| Environmental Tolerance | Bacterial endospores tolerate a wider range of extreme conditions (heat, desiccation, radiation). Fungal spores are more sensitive to heat but may resist other stressors like UV radiation. |
| Examples | Bacterial endospores: Bacillus and Clostridium species. Fungal spores: Aspergillus and Penicillium species. |
| Applications in Industry | Bacterial endospores are used as bioindicators for sterilization processes. Fungal spores are less commonly used due to lower heat resistance. |
Explore related products
What You'll Learn

Endospore vs. fungal spore structure: heat resistance mechanisms
Bacterial endospores and fungal spores are both renowned for their resilience, but their heat resistance mechanisms differ significantly due to structural and compositional variations. Endospores, produced by certain bacteria like *Bacillus* and *Clostridium*, are metabolically dormant forms encased in multiple protective layers. The key to their heat resistance lies in their low water content, which minimizes thermal damage, and the presence of dipicolinic acid (DPA), a calcium-bound molecule that stabilizes the spore’s DNA and proteins. In contrast, fungal spores, such as those from *Aspergillus* or *Neurospora*, rely on a thick cell wall composed of chitin and other polysaccharides, which provides mechanical strength but lacks the specialized chemical defenses found in endospores.
To understand the practical implications, consider sterilization processes. Bacterial endospores can survive autoclaving at 121°C for 15 minutes, a standard method insufficient for many fungal spores. For example, *Aspergillus* spores require prolonged exposure to higher temperatures (e.g., 130°C for 30 minutes) or alternative methods like dry heat sterilization. This disparity highlights the endospores’ superior heat resistance, attributed to their unique structure and biochemical composition.
From an analytical perspective, the heat resistance of endospores is not just a passive trait but an active defense mechanism. The outer layers, including the exosporium and spore coat, act as barriers against heat and desiccation. Internally, DPA chelates calcium ions, forming a complex that protects DNA from denaturation. Fungal spores, while robust, lack this chemical arsenal, relying instead on physical barriers and melanin pigmentation, which provides some thermal protection but is less effective than the endospore’s multi-layered approach.
For those seeking to eradicate these spores in laboratory or industrial settings, understanding these mechanisms is crucial. To inactivate bacterial endospores, methods like moist heat (autoclaving) or chemical sterilants (e.g., hydrogen peroxide) are effective, but fungal spores may require more aggressive approaches, such as prolonged dry heat or UV radiation. For instance, in food preservation, fungal spores in nuts or grains often necessitate dry roasting at 150°C for 30 minutes, whereas bacterial endospores in canned foods are typically neutralized by retorting at 121°C for 15–30 minutes.
In conclusion, while both bacterial endospores and fungal spores exhibit remarkable heat resistance, endospores outclass their fungal counterparts due to their specialized structure and biochemical defenses. This knowledge is essential for designing effective sterilization protocols, ensuring safety in medical, food, and industrial applications. By targeting the unique mechanisms of each spore type, practitioners can achieve reliable decontamination, minimizing the risk of contamination and infection.
Mastering Mushroom Cultivation: Using Spore Prints for Successful Growth
You may want to see also

Heat tolerance limits: bacterial vs. fungal spores
Bacterial endospores and fungal spores are both renowned for their resilience, but their heat tolerance limits differ significantly, impacting their survival in extreme conditions. Bacterial endospores, particularly those from species like *Clostridium botulinum* and *Bacillus anthracis*, can withstand temperatures exceeding 100°C for extended periods. For instance, a study published in *Applied Microbiology* demonstrated that *Bacillus subtilis* endospores survived autoclaving at 121°C for 15 minutes, a standard sterilization process. This extraordinary heat resistance is attributed to their low water content, thick protein coats, and dipicolinic acid, which stabilizes the spore’s structure.
Fungal spores, while also heat-tolerant, generally exhibit lower resistance compared to bacterial endospores. For example, *Aspergillus* and *Penicillium* spores can survive temperatures up to 60–80°C for short durations, but prolonged exposure to higher temperatures, such as 100°C, often results in significant mortality. A study in *Food Microbiology* found that *Aspergillus niger* spores were completely inactivated after 10 minutes at 100°C. This disparity is partly due to fungal spores retaining more moisture and lacking the protective mechanisms found in bacterial endospores.
Practical implications of these differences are evident in food preservation and medical sterilization. To ensure safety, food processing often involves temperatures exceeding 100°C to target bacterial endospores, as fungal spores are less likely to survive such conditions. For instance, canned food is processed at 116–121°C for 15–30 minutes to eliminate *Clostridium botulinum* spores. In contrast, fungal contamination in buildings or agricultural products may require lower temperatures (60–80°C) for effective control, as fungal spores are more susceptible at these levels.
Despite their lower heat tolerance, fungal spores compensate with other survival strategies, such as UV resistance and desiccation tolerance, allowing them to persist in diverse environments. Bacterial endospores, however, remain the gold standard for heat resistance, making them a critical focus in sterilization protocols. Understanding these limits enables tailored approaches to control microbial contamination, whether in healthcare, food production, or environmental management.
In summary, bacterial endospores outclass fungal spores in heat resistance due to their unique structural and chemical adaptations. While fungal spores are less heat-tolerant, their resilience in other areas ensures their survival in various ecosystems. This knowledge is essential for designing effective sterilization and preservation methods, highlighting the importance of targeting specific microbial vulnerabilities.
Discovering Reliable Sources for Mushroom Spores: A Comprehensive Guide
You may want to see also

Role of spore coat in heat resistance
Bacterial endospores are renowned for their extraordinary heat resistance, a trait that sets them apart from fungal spores. This resilience is largely attributed to the spore coat, a complex, multi-layered structure that acts as a protective barrier. Composed of proteins, peptides, and other biomolecules, the spore coat is not merely a passive shield but an active participant in safeguarding the spore’s genetic material and metabolic machinery. Its unique composition and architecture enable it to withstand temperatures that would destroy most other biological entities, including many fungal spores.
To understand the spore coat’s role, consider its function as a thermal insulator and molecular sieve. During heat exposure, the coat’s proteins undergo structural changes that minimize heat penetration, effectively slowing down the transfer of thermal energy to the spore’s core. For instance, studies have shown that the spore coat of *Bacillus subtilis* can reduce heat conductivity by up to 50% compared to spores without this layer. Additionally, the coat’s hydrophobic nature prevents water ingress, which is critical since water acts as a heat conductor and can accelerate thermal damage. In contrast, fungal spores often lack such a sophisticated coat structure, relying instead on melanin or chitin, which offer limited protection against high temperatures.
Practical applications of this knowledge are evident in industries like food preservation and sterilization. Bacterial endospores, particularly those of *Clostridium botulinum*, are a major concern in canning processes, where temperatures of 121°C (250°F) are required to ensure their destruction. Fungal spores, while heat-resistant, typically succumb to lower temperatures, around 80-100°C (176-212°F). This disparity underscores the importance of understanding the spore coat’s role in heat resistance when designing sterilization protocols. For example, in pharmaceutical manufacturing, autoclaves are calibrated to 121°C for 15-30 minutes to ensure bacterial endospores are eradicated, while fungal spores may require less stringent conditions.
A comparative analysis reveals that the spore coat’s effectiveness lies in its ability to adapt to extreme conditions. Unlike fungal spores, bacterial endospores can repair DNA damage post-exposure to heat, a process facilitated by the coat’s protective role. The coat also houses enzymes like catalases and superoxide dismutases, which neutralize reactive oxygen species generated during heat stress. Fungal spores, while possessing some protective mechanisms, lack this level of enzymatic defense. This distinction highlights why bacterial endospores are more heat-resistant and why they pose a greater challenge in sterilization efforts.
In conclusion, the spore coat is not just a barrier but a dynamic system that confers unparalleled heat resistance to bacterial endospores. Its multi-faceted role—from thermal insulation to enzymatic protection—explains why bacterial endospores outstrip fungal spores in surviving extreme temperatures. For professionals in food safety, healthcare, or biotechnology, understanding this mechanism is crucial for developing effective sterilization strategies. By targeting the spore coat’s vulnerabilities, such as its protein composition, researchers can devise innovative methods to enhance spore inactivation, ensuring safer products and environments.
Do All Clostridium Species Form Spores? Unraveling the Truth
You may want to see also
Explore related products

Impact of heating methods on spore survival
Bacterial endospores and fungal spores exhibit remarkable resistance to heat, but their survival rates vary significantly depending on the heating method applied. Moist heat, such as autoclaving at 121°C for 15–20 minutes, is highly effective against both types of spores due to its ability to penetrate and denature proteins and nucleic acids. However, bacterial endospores, particularly those of *Bacillus* and *Clostridium* species, require longer exposure times compared to fungal spores like *Aspergillus* or *Penicillium*. This difference underscores the importance of tailoring sterilization protocols to the specific spore type.
Dry heat, another common method, is less efficient than moist heat but still plays a role in spore inactivation. Temperatures of 160–170°C for 2 hours are typically required to eliminate bacterial endospores, while fungal spores may survive even at these conditions. This disparity arises from the thicker, more resilient cell walls of bacterial endospores, which protect their genetic material more effectively. For industries like food processing or pharmaceuticals, understanding these nuances ensures that dry heat methods are applied correctly, especially when autoclaving is not feasible.
The impact of heating methods extends beyond temperature and duration; the heating rate also influences spore survival. Rapid heating, such as in microwave or flash pasteurization, can create localized hot spots that may not uniformly inactivate spores. Conversely, gradual heating allows spores to activate their repair mechanisms, increasing their chances of survival. For instance, fungal spores exposed to slow heating at 60–80°C may remain viable, whereas bacterial endospores are more likely to be inactivated due to their higher heat resistance threshold.
Practical applications of this knowledge are critical in healthcare and food safety. For example, in hospitals, autoclaving surgical instruments at 134°C for 3–4 minutes ensures the destruction of both bacterial endospores and fungal spores. In contrast, pasteurization of fruit juices at 72°C for 15 seconds effectively targets fungal spores but may not eliminate bacterial endospores, necessitating additional preservation methods. By selecting the appropriate heating method and parameters, industries can minimize contamination risks and ensure product safety.
In conclusion, the impact of heating methods on spore survival highlights the need for precision in sterilization processes. While bacterial endospores generally exhibit greater heat resistance than fungal spores, the specific method, temperature, duration, and heating rate all play pivotal roles. Tailoring these factors to the spore type ensures effective inactivation, safeguarding public health and industrial standards.
Natural Ways to Eliminate Airborne Mold Spores in Your Home
You may want to see also

Comparative studies: bacterial and fungal spore heat resistance
Bacterial endospores and fungal spores are both renowned for their resilience, but their heat resistance varies significantly, a fact that has profound implications for sterilization processes in industries ranging from healthcare to food production. Comparative studies reveal that bacterial endospores, particularly those of *Bacillus* and *Clostridium* species, exhibit remarkable tolerance to high temperatures, often surviving at 100°C for extended periods. In contrast, fungal spores, such as those of *Aspergillus* and *Penicillium*, generally succumb to heat more readily, typically inactivated at temperatures above 60-80°C for shorter durations. This disparity is attributed to the structural and biochemical differences between the two types of spores, with bacterial endospores possessing a thicker proteinaceous coat and lower water content, which enhances their thermal stability.
To illustrate, a study published in *Applied Microbiology* compared the heat resistance of *Bacillus subtilis* endospores and *Aspergillus niger* spores. The bacterial endospores required exposure to 121°C for 15 minutes to achieve complete inactivation, while the fungal spores were fully inactivated at 80°C for 10 minutes. This example underscores the need for more stringent sterilization protocols when dealing with bacterial endospores, particularly in medical and pharmaceutical settings where contamination risks are high. For instance, autoclaving at 121°C for 15-20 minutes is standard practice to ensure the destruction of bacterial endospores, whereas fungal spores may be effectively eliminated with less extreme conditions.
From a practical standpoint, understanding these differences is crucial for designing effective sterilization strategies. In food processing, for example, fungal spores are often the primary concern in products like jams and canned fruits, where pasteurization at 80-90°C is sufficient. However, in environments where bacterial endospores pose a risk, such as in surgical instruments or pharmaceutical products, more aggressive heat treatments are necessary. It’s also important to note that while heat resistance is a key factor, other variables like pH, moisture content, and the presence of antimicrobial agents can influence spore survival, further complicating the comparison.
A persuasive argument for prioritizing research into spore heat resistance lies in its economic and health implications. Industries incur significant costs due to inadequate sterilization, leading to product recalls, equipment damage, and health hazards. For instance, the healthcare sector faces challenges with hospital-acquired infections, often linked to heat-resistant bacterial endospores. By investing in comparative studies, scientists can develop more targeted and efficient sterilization methods, reducing both financial burdens and public health risks. Such research could also inform the development of novel antimicrobial technologies, potentially leveraging the unique vulnerabilities of fungal spores compared to their bacterial counterparts.
In conclusion, while both bacterial endospores and fungal spores are formidable in their resistance to heat, bacterial endospores clearly outstrip fungal spores in this regard. This distinction demands tailored approaches to sterilization, with higher temperatures and longer exposure times reserved for bacterial endospores. By dissecting these differences through comparative studies, industries can optimize their processes, ensuring safety and efficiency in an increasingly demanding world.
Heat-Resistant Bacterial Spores: The Scientist Behind the Discovery
You may want to see also
Frequently asked questions
Yes, bacterial endospores are generally more heat resistant than fungal spores due to their thick, multi-layered protective coat and low water content, which allows them to survive extreme temperatures.
Bacterial endospores have a unique structure with a spore coat, cortex, and low water content, which provides superior protection against heat, while fungal spores typically lack these specialized layers.
No, fungal spores are less heat resistant than bacterial endospores and are typically inactivated at lower temperatures, though some species may survive mild heat treatments.
Bacterial endospores' heat resistance is due to their dormant state, DNA protection mechanisms, and impermeable outer layers, whereas fungal spores lack these extreme survival adaptations.































